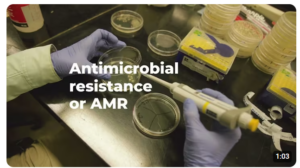

๐๐๐’๐ ๐ช๐ผ๐ฟ๐น๐ฑ ๐๐ป๐๐ถ๐บ๐ถ๐ฐ๐ฟ๐ผ๐ฏ๐ถ๐ฎ๐น ๐๐๐ฎ๐ฟ๐ฒ๐ป๐ฒ๐๐ ๐ช๐ฒ๐ฒ๐ธ.
Antimicrobial resistance (๐๐ ๐ฅ) is not a distant threat โ itโs happening today and the data speaks volumes.
๐ฆ๐๐ถ๐ฝ๐ฒ ๐๐ต๐ฟ๐ผ๐๐ด๐ต to see the staggeringย ๐ถ๐บ๐ฝ๐ฎ๐ฐ๐ of antimicrobial drug resistance, particularly on ๐ฐ๐ฎ๐ป๐ฐ๐ฒ๐ฟ ๐ฝ๐ฎ๐๐ถ๐ฒ๐ป๐๐.
๐ง๐ผ๐ด๐ฒ๐๐ต๐ฒ๐ฟ, we must strengthen awareness, stewardship, and innovation to preserve the effectiveness of antibiotics โ and the future of global health.